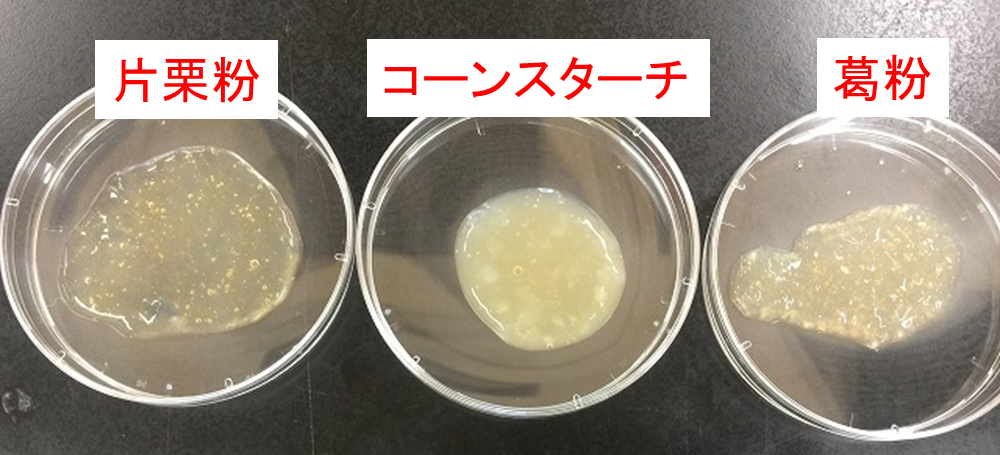

N 幕 お好み焼き 白フチ木看板風 No.28045 受注生産☆3繁盛支援カタログVol.14 P142幕,大漁旗,木製看板風バナーのぼり屋工房 オンラインカタログ。
お好み焼き 屋 看板 (461 無料画像)
平野西に お好み焼き えっちゃん 近日オープンです。大阪看板堂大阪の看板製作各種切文字対応可能 金属文字 アクリル文字 カルプ文字 木彫り文字。
お好み焼はここやねん、10月2日にオープンやねん。店、だいぶできてきてんねん。 茨木ジャーナル いばジャル。
お好み焼き店の看板 かんばん劇場のかっぱ橋石山製作所。
倉敷市 平田に「お好み焼きひらたや」が3月8日オープン。看板できてる。
お好み焼き屋ロゴ・看板デザインのご依頼・制作の紹介 - SANTEN Design。
飲食店 大阪府豊中市のお好み焼き屋。間口一杯に看板制作を行い新規客の獲得に成功大阪・堺市の集客出来るデザインの看板屋 インプレッセ。
のぼり屋工房 ☆N_幕 28045 お好み焼き 白フチ木看板風 750×585mm トロピカル 集客 販促品 : ワークウエイト - 通販 -Yahoo!ショッピング。
飲食店 大阪府豊中市のお好み焼き屋。間口一杯に看板制作を行い新規客の獲得に成功大阪・堺市の集客出来るデザインの看板屋 インプレッセ。
老舗お好み焼き屋さんの移転に伴うサイン工事プラスアート株式会社大阪のオシャレな看板デザイン製作。
地元姫路にあるお好み焼き屋とんとんの看板を描きかえました!ブログ全国対応スプレーアート壁画制作スタジオ BOMBG WORLD。
お好み焼き屋ロゴ・看板デザインのご依頼・制作の紹介 - SANTEN Design。
赤提灯 お好み焼き文字入り 株式会社ゾーンプラス 美容・家電・生活雑貨商材の総合卸販売。
う〇ちいっぱい」!? 衝撃の看板文字、実は滋養たっぷり「薬膳お好み焼き屋」だったまいどなニュース。
お好み焼きHATAYA-ハタヤ-おしゃれな のぼり旗 看板 専門店。
広島焼の看板を掲げたお好み焼き屋。人 畜 無 害。
美味しそうなお好み焼きの看板があるお好み焼き屋さんの建物イラスト・鉄板焼き・経営・個人経営のイラスト素材89593925- PIXTA。
お好み焼 鉄板焼 やつなみ 八丁堀 幟町 白島 お好み焼き・もんじゃ ネット予約可ヒトサラ。
お好み焼き 看板イラスト無料イラスト・フリー素材なら「イラストAC」。
ロゴ制作事例 - お好み焼き・鉄板焼きレストランのロゴデザインASOBOAD。
お好み焼き屋さんの看板施工名古屋の看板屋ニッカブログ。
デザイン看板・印刷 種類豊富でコストパフォーマンスの高い食べ放題!が人気のお好み焼き屋さんkanagawashonandaiデザイン看板屋 Signpostブログ。
楽天市場 お客様専用 駐車場 看板 プレート お好み焼き 鉄板焼き 屋号 店舗用 名前 ネームプレート おしゃれ かわいい 駐車禁止 迷惑駐車無断駐車 対策 番号 数字 案内 矢印 名札 制作 作成 目立つ パーキング シンプル 屋外用 横 W300×H100mm : イヌのかんばんや。
地元姫路にてお好み焼き屋さんの看板を描き替え中です✨ブログ全国対応スプレーアート壁画制作スタジオ BOMBG WORLD。
お好み焼き鉄板焼き・いなほや ホームメイト。
お好み焼 清十郎 清十郎ミックス玉お好み焼き 清十郎スペシャルもんじゃ魔人の食日記。
お好み焼き・鉄板焼き店の看板デザイン広島のデザイン事務所 K'sデザイン室 K's DESIGN。
お好み焼本舗 看板商品「串カツ」が登場!新グランドメニューの販売開始!!株式会社物語コーポレーションのプレスリリース。
なんでこんなトコで?お好み焼き屋「どかどか」@生野区林寺: こんなの食べたよ。
もん字屋さまの欄間看板と壁面看板看板デザイン・アイデアラボ。
お好み焼き 鉄板焼き やのや様 店舗看板 - 千葉・東京の野立看板・屋外看板株式会社アイル。
Lサイズ オーダー無料 お好み焼き 営業中 テイクアウト 店舗 キッチンカー ランプ 照明 看板 置物 雑貨 ライトBOXiichi日々の暮らしを心地よくするハンドメイドやアンティークのマーケットプレイス。
お好み焼き屋の自作看板。人 畜 無 害。
楽天市場 お好み焼き 看板の通販。
鉄板と看板鉄板入りました! 一般に広島のお好み焼きは15~19㎜の特注鉄板を使いますが、これは更に上回る22㎜の鉄板を使用。蓄熱が大きく美味しく焼けるはず!?看板も付けてもらってお店らしくなってきました!鉄板焼き特注クレープ屋さん。
オリジナル看板作製 おいしいお好み焼き店 神奈川県 大和市看板デザイン看板屋Signpostブログ。
お好み焼き店の看板 かんばん劇場のかっぱ橋石山製作所。
Amazon看板 お好み焼き 秘伝の味 味自慢 当店自慢 立て看板 木枠看板 告知看板 案内看板 NDS_0842店舗看板文房具・オフィス用品。
喃風 姫路本店本店の旅。
東香里新町に「笑いや」っていうお好み焼き・鉄板焼き屋ができてる - 枚方つーしん。
お好み焼本舗 5日間限定!新メニュー販売記念キャンペーンを開催株式会社物語コーポレーションのプレスリリース。
広島お好み焼きの王道を体感できる場所”昭和32年に創業され、屋台時代から約65年以上の歴史を誇る老舗お好み焼き屋 さん 麗ちゃん が地元民からも観光客からも愛される稀有な存在のお好み焼き屋さんだった🍽️ - 想い出のメモリーBlog。
お好み焼き屋:イラスト無料。
横川町にあるお好み焼き屋さん どんどんへ😀久々に来店👣 ふっくらでジューシーな一枚は、 いつ食べても美味しいです♪ ご馳走様でした😋明日は10時から1時までの営業です👩💼広島お好み焼きどんどんどんどんお好み焼き美味しい横川町s78。
通天閣本通商店街にお好み焼き店「どやさ」-看板メニューは「ネギ焼き」 - あべの経済新聞。
お好み焼き屋ロゴ・看板デザインのご依頼・制作の紹介 - SANTEN Design。
お好み焼き・鉄板焼 ばると事例紹介商業施設・店舗デザイン・アーケード・商店街の設計、施工なら、ストアコレクションへ。
デザイン看板 もんじゃ×お好み焼きをワイワイ楽しめる鉄板居酒屋。東京新宿デザインファサード看板デザイン看板屋 Signpostブログ。
やひろ様のスタンド看板福岡の看板制作専門ダイキサイン。
TOP。
お好み焼き屋の看板!大阪の看板屋!看板の製作、取付奮闘記。
大阪市淀川区 源ぺい跡地 西側のお好み焼 鉄板焼のお店の看板が赤から白へ変わっていました。号外NET 淀川・西淀川。
お好み焼き 匠 ロゴ制作制作実績ROCK DESIGN ロックデザイン-広島近郊でホームページ・印刷物・サイン看板などデザインの事なら。
呉市 団地の中の小さなお好み焼き屋さん「お好み焼き ぐぅ。」のお好み焼きをいただきました!号外NET 呉市・江田島市。
小牧山の目の前にある「甚」。リーズナブルなお好み焼き屋 小牧市間々本町: 小牧つーしん。
看板製作事例:和柄がかわいいお好み焼き屋さんの店頭用電飾看板を製作しました! - サインモール。
デザイン看板 種類豊富でコストパフォーマンスの高い食べ放題!が人気のお好み焼き屋さんkanagawashonandaiデザイン看板屋 Signpostブログ。
okeikoJapan宮島のスタッフおすすめグルメ!「くらわんか」お好み焼き株式会社okeikoJapan。
お好み焼きの屋台の看板の写真素材49444968- PIXTA。